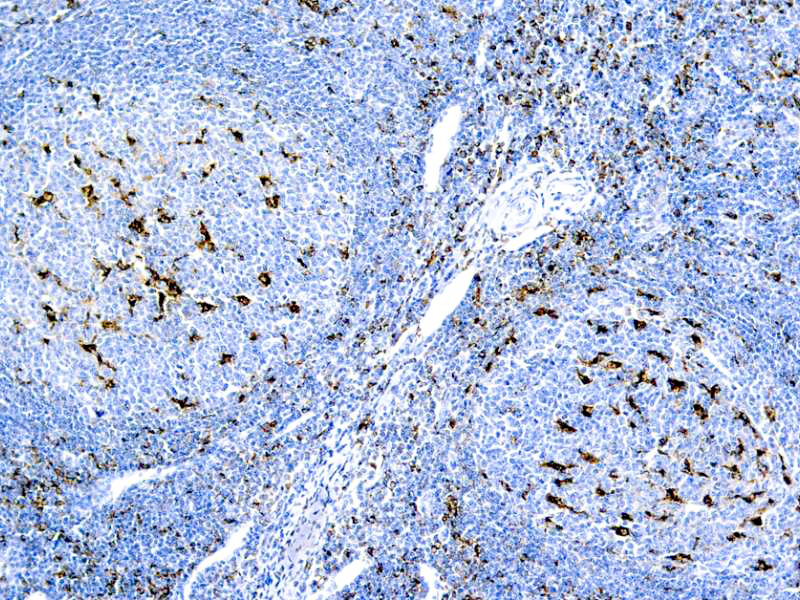

CD68, Macrophage (KP1)
Description
This antibody recognizes a glycoprotein of 110kDa, which is identified as CD68. It is important for identifying macrophages in tissue sections. It stains macrophages in a wide variety of human tissues, including Kupffer cells and macrophages in the red pulp of the spleen, in lamina propria of the gut, in lung alveoli, and in bone marrow. It reacts with myeloid precursors and peripheral blood granulocytes. It also reacts with plasmacytoid T cells, which are supposed to be of monocyte/macrophage origin. It shows strong granular cytoplasmic staining of chronic and acute myeloid leukemia and also reacts with rare cases of true histiocytic neoplasia. Lymphomas are negative or show few granules.
Additional information
| Clone | KP1 |
|---|---|
| Isotype | IgG1, kappa |
| Immunogen | Subcellular fraction of human alveolar macrophages. |
| Species | Mouse |
| Cellular Localization | Cytoplasmic |
| Positive Control Tissue | Tonsil |
| Pretreatment | EDTA Buffer pH 8.0 (Manual/ Montage) |
| Incubation & Temperature | 30 min @ RT |
| Intended Use | IVD |
| Detection System | PolyVue™ Plus – Two Step Detection System or Montage PolyVue Plus™ Auto Detection System for Montage 360 System or HighLighter core kit for HighLighter Staining System |
| Description/Type | Mouse Monoclonal Antibody |
| Format | This product is supplied as a purified immunoglobulin and contains sodium azide as a preservative. |
DATASHEETS & SDS
DATASHEETS & SDS
| Download Datasheet |
| Download SDS Sheet – OSHA |
REFERENCES
REFERENCES
- Micklem et al. Br J Haematol 73: 6, 1989.
- Pulford et al. J Clin Pathol 42: 414, 1989.
- Ruco et al. Am J Clin Pathol 92: 273, 1989.
- Warnke et al. Am J Pathol 135: 1089, 1989.
Reviews (0)
Only logged in customers who have purchased this product may leave a review.

Reviews
There are no reviews yet.